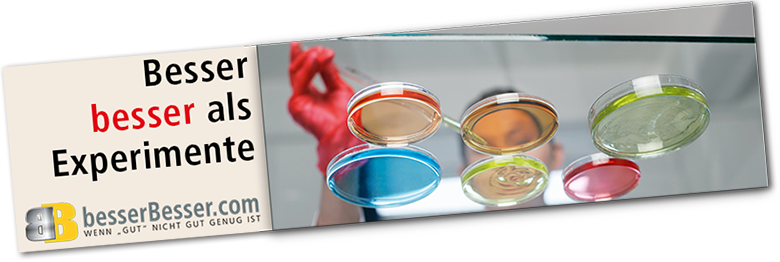
SEO Tests

Weil wir die meisten unserer semantischen Domains schon vor 2000 registriert haben, können wir besondere Mailadressen / Subseiten / Subdomains anbieten.
Bessere Suchergebnisse hängen auch von starken e Mail Adressen / Subseiten und SubDomains ab.

Wenn "gut nicht gut genug" ist, sollte die Argumentation für eine Lösung schon bei der Mailadresse beginnen**.

** Mailadressen können konventionell genutzt werden oder themenbezogen, automatisch antworten.
Z.B.: rezeption@hotelissimo.com oder mode@zumfreuen.com. Probieren Sie's aus!

Unsere Arbeit ist nachvollziehbar erfolgreich, weil wir ...
 mit allen Tools seit Jahren selbst erfolgreich arbeiten!
mit allen Tools seit Jahren selbst erfolgreich arbeiten!
 in verschiedenen Branchen (Gastronomie, Spitäler, Sanitär, Immobilien, Handel, Onlinemarketing, ...) seit über 20 Jahren sehr gut vernetzt sind.
in verschiedenen Branchen (Gastronomie, Spitäler, Sanitär, Immobilien, Handel, Onlinemarketing, ...) seit über 20 Jahren sehr gut vernetzt sind.
 seit einigen Jahren auch Werbeagenturen zu diesen Themen beraten.
seit einigen Jahren auch Werbeagenturen zu diesen Themen beraten.

Ihr Engagement können wir entscheidend unterstützen!
Seit 25 Jahren betreiben wir mehrere,
große Homepage-Projekte. Knapp
100.000 Seiten* und spezielles know-how sorgen dafür, daß Informationen und Angebote für Produkte, Projekte, Services, ... online sehr gut gefunden werden.
Wir gehen ...

eigene, erfogreiche Wege im Suchmaschinenmarketing

entwickeln dafür spezialisierte, neue Tools / Strategien

schaffen individuelle Kommunkations-Kanäle.
Engagiert, professionell, verläßlich.
* zum Teil in sechs Sprachen

Online-Erfolg hängt von besseren Suchergebnissen ab,
SEO erhöht die Sichtbarkeit einer Website und deren Inhalte.
SEM / Suchmaschinenmarketing hilft die Besucherfrequenz von Internetseiten hochzutakten.

Beide haben auch im Tourismus grosses Potential!